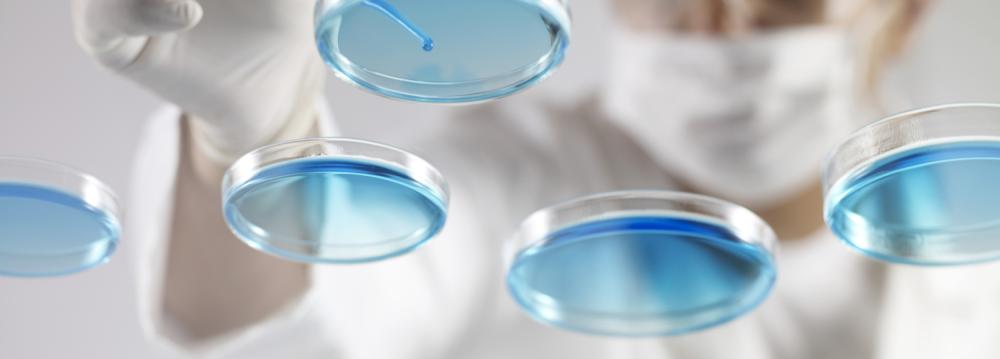

Scientists have found dangerous drug-resistant “super bacteria” off beaches in Rio de Janeiro that will host Olympic swimming events and in a lagoon where rowing and canoe athletes will compete when the games start on Aug. 5.
The findings from two unpublished academic studies seen by Reuters concern Rio’s most popular spots for tourists and greatly increase the areas known to be infected by the microbes normally found only in hospitals.
They also heighten concerns that Rio’s sewage-infested waterways are unsafe.
A study published in late 2014 had shown the presence of the super bacteria - classified by the US Centers for Disease Control and Prevention as an urgent public health threat - off one of the beaches in Guanabara Bay, where sailing and wind-surfing events will be held.
The first of the two new studies, reviewed in September by scientists at the Interscience Conference on Antimicrobial Agents and Chemotherapy in San Diego, showed the presence of the microbes at five of Rio’s showcase beaches, including the ocean-front Copacabana, where open-water and triathlon swimming will take place.
The other four were Ipanema, Leblon, Botafogo and Flamengo.
Bacteria Kills Half of the Infected Patients
The super bacteria can cause hard-to-treat urinary, gastrointestinal, pulmonary and bloodstream infections, along with meningitis. The CDC says studies show that these bacteria contribute to death in up to half of patients infected.
The second new study, by the Brazilian federal government’s Oswaldo Cruz Foundation lab, which will be published next month by the American Society for Microbiology, found the genes of super bacteria in the Rodrigo de Freitas lagoon in the heart of Rio and in a river that empties into Guanabara Bay.
Waste from countless hospitals, in addition to hundreds of thousands of households, pours into storm drains, rivers and streams crisscrossing Rio, allowing the super bacteria to spread outside the city’s hospitals in recent years.
Renata Picao, a professor at Rio’s federal university and lead researcher of the first study, said the contamination of Rio’s famous beaches was the result of a lack of basic sanitation in the metropolitan area of 12 million people.
“These bacteria should not be present in these waters. They should not be present in the sea,” said Picao from her lab in northern Rio.
Cleaning the city’s waterways was meant to be one of the games’ greatest legacies and a high-profile promise in the official 2009 bid document Rio used to win the right to host South America’s first Olympics.
Rio state’s Inea environmental agency said it follows the World Health Organization’s recommendations for testing recreational water safety, and that searching for super bacteria was not included.